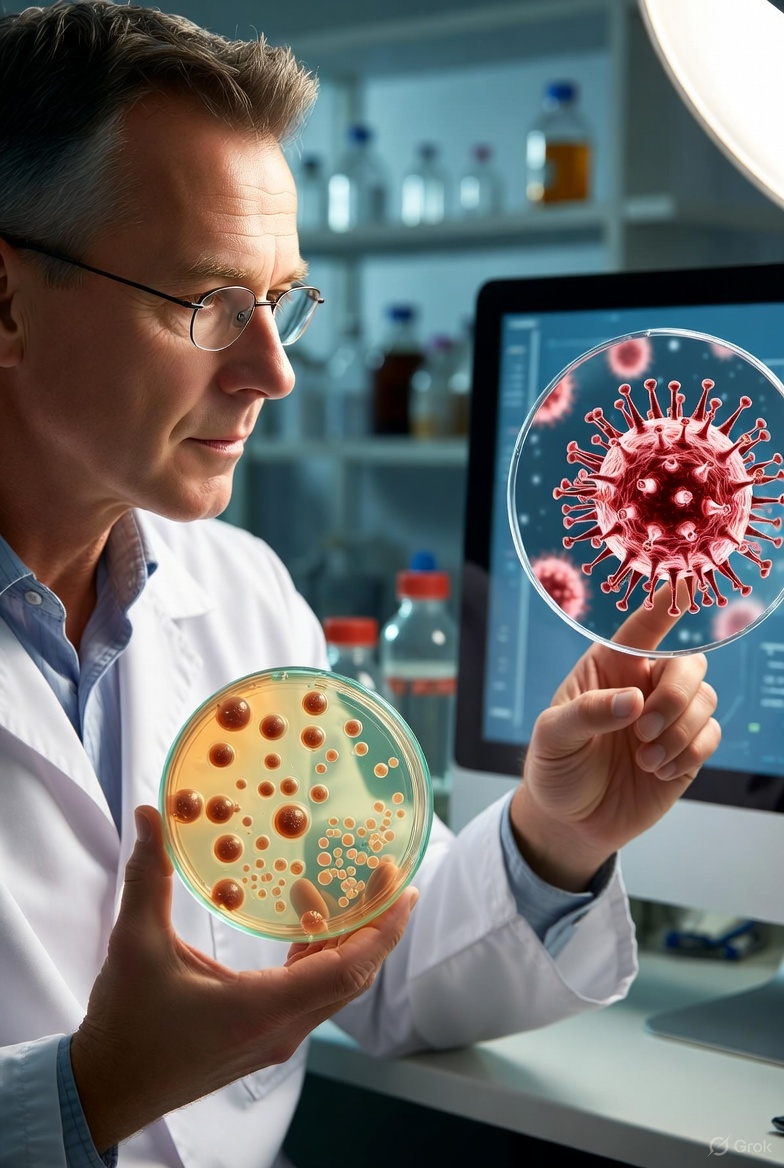
🦠 Mikrop ve Virüs Arasındaki Fark

🦠 Mikrop ve Virüs Arasındaki Fark
📅 2025-11-11
Günlük hayatta sıkça kullandığımız mikrop ve virüs kavramları çoğu zaman birbirine karıştırılır. Ancak bu iki mikroorganizma türü hem yapısal hem de davranışsal olarak oldukça farklıdır. Bu farkları bilmek, hastalıkların bulaşma ve tedavi süreçlerini anlamada büyük önem taşır.
Mikrop Nedir?
Mikroplar, gözle görülemeyen küçük canlılardır. Bakteriler, mantarlar ve bazı parazitler mikrop grubuna girer. Kendi başlarına çoğalabilirler ve uygun ortamda hızla yayılırlar. Çoğu mikrop zararsızdır hatta bazıları sindirim sistemi için faydalıdır. Ancak zararlı bakteriler enfeksiyonlara neden olabilir. Örneğin boğaz enfeksiyonlarına neden olan Streptococcus bakterisi bir mikroptur.
Virüs Nedir?
Virüsler ise canlı hücrelerin içinde çoğalabilen mikroskobik yapılardır. Kendi başlarına yaşama yetenekleri yoktur. Bir hücreye girip kontrolünü ele geçirerek çoğalırlar. Bu yüzden virüs kaynaklı hastalıkların tedavisi zordur. Antibiyotikler virüslere etki etmez, çünkü antibiyotikler sadece bakterilere karşı etkilidir.
Enfeksiyon Farkı
Bakteriyel enfeksiyonlar genellikle antibiyotikle tedavi edilirken, viral enfeksiyonlarda bağışıklık sistemi devreye girer. Virüsleri yenmenin en etkili yolu, vücudun savunma mekanizmasını desteklemektir. Bu nedenle istirahat, bol sıvı ve bağışıklığı güçlendirici besinler önemlidir.
Eczane Tavsiyesi
Hastalığın nedeni bilinmeden ilaç kullanmak sakıncalıdır. Eczaneler, semptomlara göre uygun ürünler ve vitamin takviyeleri hakkında yönlendirme yapabilir. Ayrıca probiyotikler bağırsak florasını destekleyerek hem bakteriyel hem viral enfeksiyonlara karşı koruyucu etki gösterir.
Korunma Yöntemleri
Ellerin sık yıkanması, dengeli beslenme, yeterli uyku ve stresin azaltılması hem mikrop hem de virüs kaynaklı hastalıkların önlenmesinde büyük rol oynar. Ayrıca mevsimsel aşılar (örneğin grip aşısı) virüslere karşı önemli bir kalkan oluşturur.
Sonuç olarak, her mikrop zararlı değildir ama virüsler mutlaka hücreye zarar verir. Aradaki farkı bilmek, doğru korunma ve tedavi yöntemlerini seçmenin ilk adımıdır.
Kaynak: Nöbetçi Eczane Ara Sağlık Rehberi